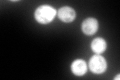
YDR099W
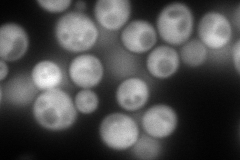
YDR099W
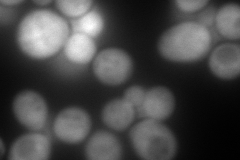
YDR099W
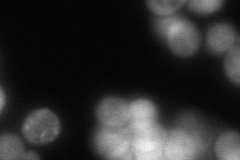
YDR099W
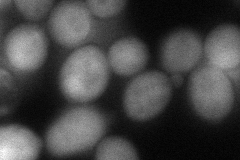
YDR099W
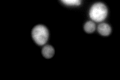
YDR099W
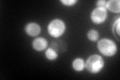
YDR099W

View description
14-3-3 protein, minor isoform; controls proteome at post-transcriptional level, binds proteins and DNA, involved in regulation of many processes including exocytosis, vesicle transport, Ras/MAPK signaling, and rapamycin-sensitive signaling
Localization:
Intensity:
Fold change:
Significance:
-
C’ GFP library in SD
cytosol352.55 -
N' NOP1pr-GFP in SD
cytosol288.838 -
N' TEF2pr-mCherry in SD
cytosol370.228 -
N' NATIVEpr-GFP in SD
cytosol149.431 -
N' TEF2pr-VC and Cyto-VN in SD
cytosol80.1062 -
C’ GFP library in SD+DTT
cytosol533.011.51Yes -
C’ GFP library in SD+H2O2

cytosol441.321.25No -
C’ GFP library in Starvation Media
cytosol606.51.72Yes -
C’ GFP library on the background of Pup2-DaMP

cytosol -
C’ GFP library on the background of CCT mutant

cytosol414.931.17692No
